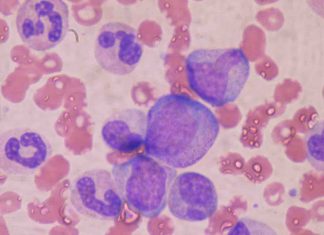
Study: Bone marrow backup needed to tackle respiratory infections Study: Bone marrow backup needed to tackle respiratory infections

Dealing With Negative Emotions and Depression From Lyme and Other Illnesses
When journeying through the maze of Lyme disease, it is as if you are journeying through innumerable diseases all at once -MS, A.L.S., depression,...
Research examines outcomes of plug-based and suture-based vascular closure following TAVR...
Results from the largest randomized trial available comparing different closure device strategies following transcatheter aortic valve replacement (TAVR) found that a plug-based vascular closure...
Cystic fibrosis study shows bacterial evolution for the first time
Physicians and researchers have been fighting a continuing battle against invasive bacteria that can cause the development of complications in people that have cystic...
Study: Bone marrow backup needed to tackle respiratory infections
Scientists at the Francis Crick Institute have found how the immune system triggers an ‘emergency’ dendritic cell response during infection, with dendritic cells at...
Drunk driving doubles in people that use alcohol and pot at...
The first study of its kind shows that people who smoke marijuana and consume alcohol at the same time over a year or more...
Study shows anxiety produces detrimental brain plasticity
Brain plasticity that leads to the over-generalization of external events has been found to be a common characteristic of anxiety for the first time....
Genetic malfunction in peripheral nerves may be the cause of autism
The majority of research into the causes of autism has concentrated on the brain. David Ginty, a Professor of Neurobiology at Harvard Medical School...
What makes great chocolate is fermentation of the cocoa beans
Fermentation of cocoa beans requires precise collaboration among two types of bacteria, and yeast, says new research on what makes great chocolate. The new...
Researchers discover how our brain uses nutritional state to regulate growth...
Cambridge scientists have discovered how a receptor in the brain, called MC3R, detects the nutritional state of the body and regulates the timing of...
Holistic wellness for ADD and ADHD addresses emotions, elements, and environment
In modern society we are overloaded with stimulation and instant gratification. We can use technology to get information about any topic instantly, we can...